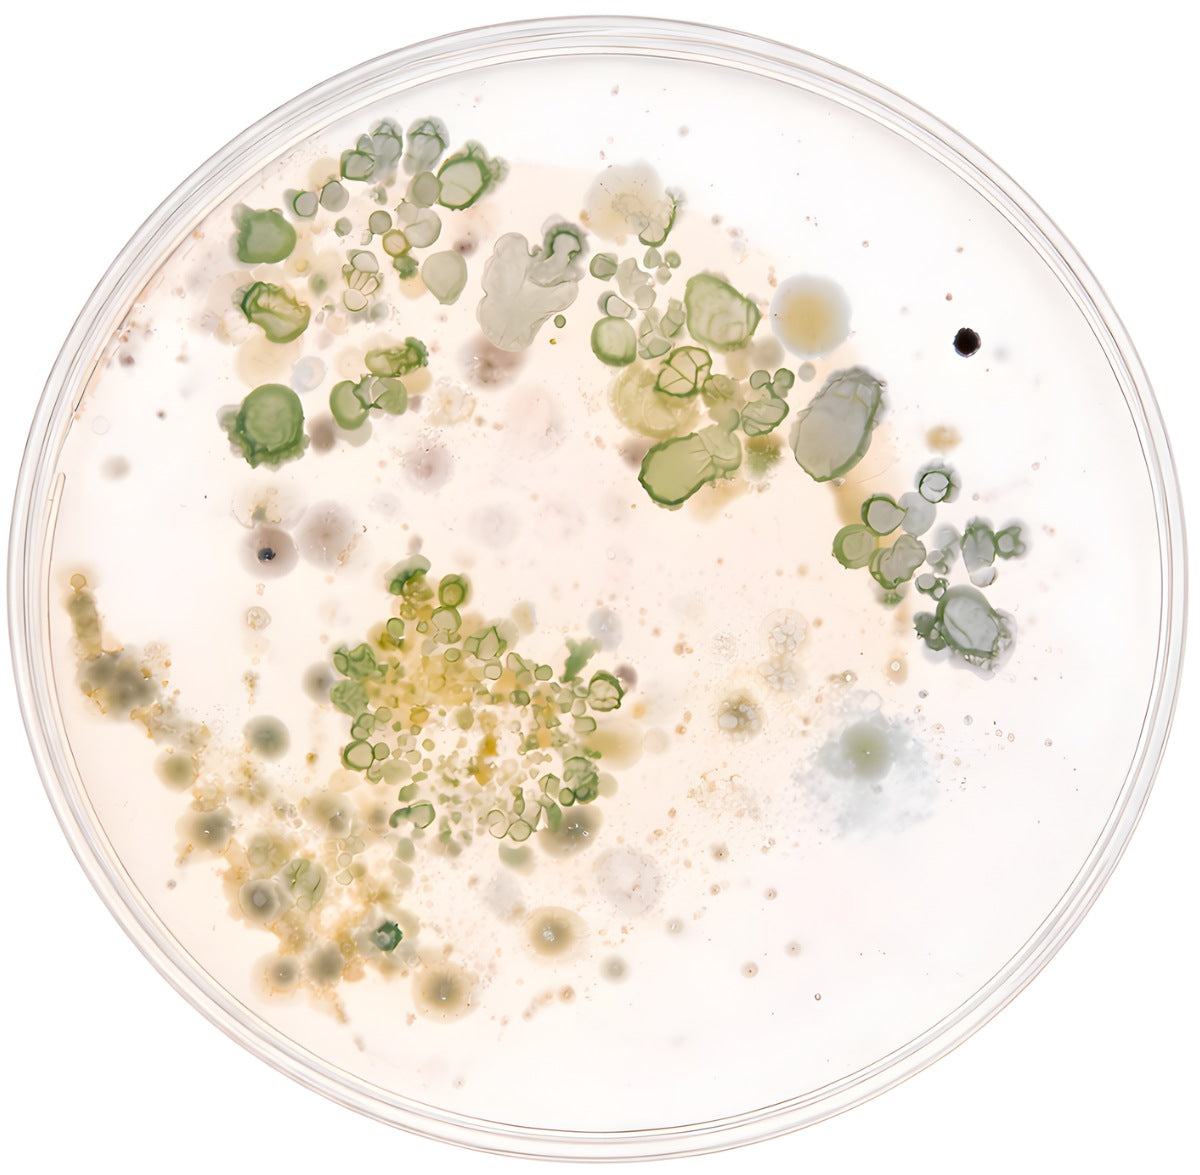

When regulation becomes harder
Most changes women experience aren’t about discipline. They’re about biology. As hormones shift and the gut microbiome changes, the signals that once helped the body maintain balance begin to quiet.
Not broken. Just interrupted.
And interrupted systems can be restored.
What the signal loss looks like

Restores Gut Signaling

Supports Hormonal Rhythm

Fat Pathway Activation

Calms Inflammation
Patented Strains for Fat Regulation
Kurva Pro, explained
- 12+ double-blind human clinical trials
- Fat-burning pathways activated through precision strain science
- Restoring the gut signals modern diets disrupted
IPC INNOVATION AWARD · INT'L MICROBIOME RESEARCH CONFERENCE
They didn't expect it to work this fast.
GROUNDED IN SOUTH KOREAN FERMENTATION
Precision over strain overload
Source & Selection
Derived from traditional kimchi fermentation and the gut profiles of healthy women shaped by South Korea's lifelong fermentation culture. Not from excess strain formulas designed to impress on a label.
Restored Gut Signaling
Re-establishes gut-driven signals many modern bodies no longer receive, supporting the body’s natural rhythm and fat regulation.
Metabolic & Weight Regulation
Engages gut-driven pathways involved in fat distribution and biological balance. Naturally.
Inflammation & Digestive Comfort
Soothes gut-driven inflammatory activity that can interfere with digestive comfort and metabolic flow.

Probiotics
Precision-selected strains that engage gut-driven signaling and support the regulation of fat-related pathways.
- · Reduces bloating
- · Supports metabolic balance
- · Targets visceral fat pathways
Prebiotics
A citrus-derived prebiotic shown to nourish beneficial bacteria and reinforce gut-driven signaling within the digestive tract.
- · Reduces puffiness
- · Digestive comfort
- · Gut stability
Synbiotic
A next-generation synbiotic designed to restore the gut-driven signals behind metabolic balance.
- · Probiotic: clinically validated
- · Prebiotic: clinically validated
- · Engineered for weight regulation

YOU'RE NOT DOING THIS ALONE
7-Day Deflammatory Kickstart
Guided by ēvene's in-house functional medicine nutritionist and shaped by years of real-world clinical experience, the Kickstart helps fast-track your progress through simple food guidance that calms inflammation and supports your gut from day one.
Alongside a private community of women starting from the same place.













